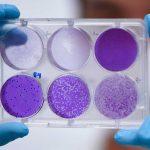

Spain’s Foreign Minister, Arancha González, said Monday the country’s latest national figures show the Coronavirus’s upwards curve appears to be flattening out.
The Spanish authorities have confirmed 6,398 more cases of coronavirus. This brings the total to 85,195 – higher than that of China, where the outbreak began.
Another 812 deaths have also been reported. The national total now stands at 7,340, making Spain the worst-affected country in the world behind Italy.
Madrid, Catalonia and the Basque region remain the hardest-hit areas.
But there is some good news: the number of new confirmed cases is the lowest reported for a week.
Ms González said pressure on intensive care units remained the biggest challenge, and new restrictions would help contain the spread.
The foreign minister also said it was unfair to single out Spain because other countries – including Italy and the US – were also dealing with unprecedented numbers.